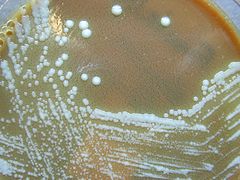

الفرنسيسلة التولارية
| Francisella tularensis | |
|---|---|
| |
| F. tularensis colonies on an agar plate. | |
| التصنيف العلمي | |
| مملكة: | |
| Phylum: | |
| Class: | |
| Order: | |
| Family: | Francisellaceae
|
| Genus: | |
| Species: | F. tularensis
|
| Binomial name | |
| Francisella tularensis (McCoy and Chapin 1912)
Dorofe'ev 1947 | |
الفرنسيسلة التولارية Francisella tularensis، هي جراثيم سلبية الگرام *تسبب مرض التولاريميا Tularemia وهو نوع من الحمى. [1] Due to its ease of spread by aerosol and its high virulence, F. tularensis is classified as a Class A agent by the U.S. government.[2]
الوصف
- هذا الجرثوم هو عصية صغيرة أبعادها حوالي 1 ميكرون.
- عصيات سلبية الغرام.
- لها سوط قطبي.
- غير متحركة وغير مبوغة.
- ليس لها محفظة.
- هوائية مجبرة.
- تنمو على المستنبتات العادية.
- تفضل جو 10% Co2
الصفات البيوكيميائية
- الكاتالاز سلبي.
- تحرير H2S إيجابي (تعطي راسب بلون أسود عند وجود معدن مثل الحديد في وسط الزرع).
- تخمر السكاكر بدون إطلاق غاز.
مستضدات الجرثوم
- تملك مستضد جسمي Lps) O، ويتشكل منه عدة أنماط مصلية Serotype ويمكن استخدام هذه المستضدات بتفاعل تشخيص مصلي (تفاعل تحوصب) والعيار الذي نأخذه بعين الاعتبار 1/ 20، وبعض المراجع تقول بأنه يجب أن يكون العيار 1/40 وما فوق.
- يملك الجرثوم مستضد آخر وهو الـ tularen والذي يسبب فرط تحسس متأخر
ويمكن كشفه عن طريق تفاعل تحت الجلد فالبنسيلين مثلاً يسبب فرط تحسس فوري (تفاعلات أضداد تحسسية) أما بحالة هذا المستضد ففرط التحسس متأخر وبالتالي الأضداد لن تعمل بمثل هذه الحالة وإنما ستعمل الخلايا (تفاعل خلايا ممنعة (متحسسة)).
انتقال المرض
المرض هو الحمى المتماوجة deerfly fever ينتقل إما مباشرة (نادراً) عن طريق الجلد المسحوج (الجروح والقروح) أو عن طريق لدغ الحشرات كالقمل والذباب والقوارض (الأكثر تواتراً)وهي نفسها يمكن أن تشكل مستودعاً له حيث تعيش فيها هذه الجراثيم بشكل دائم وخاصة في المناطق الموبوءة. ويمكن أن تنتقل العدوى من الأيدي الملوثة، في حال وجود جروح أو خدوش.
أعراض المرض
أعراض حمى متماوجة (ارتفاع وانخفاض بالحرارة).
- موضعية مكان دخول الجرثوم.
- عينية وذلك في حالة الأيدي الملوثة، لأن العين حساسة، ففي حالة باقي مناطق الجسم فلا ينتقل الجرثوم بدون خدوش، أما أغشية العين فهي ضعيفة.
- أعراض جلدية وهضمية.
- يمكن بدخول الجرثوم عن طريق التنفس أن يصل للدم، وهناك يسبب:
تجرثم دم قد يكون شديد أو خفيف حسب مقاومة الشخص.
- حمى وارتفاع حرارة.
- صداع.
- حمى متماوجة، أي تتماوج فيها الأعراض قليلاً، فتنخفض الحرارة وترتفع.
التشخيص
مباشر
وذلك ببزل العقد اللمفاوية في منطقة دخول الجرثوم.
زرع الدم
ويحتاج الجرثوم في حالة الزرع لفترة حضانة من 5 – 7 أيام.
غير مباشر
عن طريق التفاعلات المصلية، وهي تشخص بعد 15 يوم من الإصابة، حيث تكون قد تشكلت الأضداد. وعيار المصل يجب أن يكون أعلى من 1/20.
المصادر
- ^ Ryan KJ; Ray CG (editors) (2004). Sherris Medical Microbiology (4th ed.). McGraw Hill. pp. 488–90. ISBN 0-8385-8529-9.
{{cite book}}:|author=has generic name (help)CS1 maint: multiple names: authors list (link) - ^ Oyston P, Sjostedt A, Titball R (2004). "Tularaemia: bioterrorism defence renews interest in Francisella tularensis". Nat Rev Microbiol. 2 (12): 967–78. doi:10.1038/nrmicro1045. PMID 15550942.
{{cite journal}}: CS1 maint: multiple names: authors list (link)
وصلات خارجية
- Francisella tularensis information from the CDC/National Center for Infectious Diesase:
- BioHealthBase Bioinformatics Resource Center The National Institute of Allergy and Infectious Disease (NIAID) supports a public database describing the molecular genetics of F. tularensis. The website describes the genes, proteins, and cellular characteristics of the pathogen.